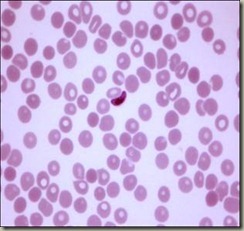

PARASITOLOGI-MORFOLOGI P. falciparum, P. vivax,
P. malariae, & P. ovale
Plasmodium falciparum
| Peringkat | Huraian |
| Trofozoit awal | ü Bentuk cincin ü Saiz : 1/5 daripada RBC ü Bentuk : pelbagai § Accole – di atas RBC § 2 titik kromatin § infeksi berganda (parasetemia) ü tiada pigmen ü |
| Trofozoit matang | ü jarang kelihatan dalam darah periferi ü saiz kecil ü eritrosit TIDAK membesar ü terdapat bintik-bintik ‘MAURERS CLEFT’ ü besar & sedikit (8-10) ü boleh akibat krenasi dalam RBC (jarang) |
| Skizon awal | ü jarang terdapat dalam darah periferi ü saiz hampir memenuhi RBC ü eritrosit tidak membesar ü bentuk padat ü kromatin banyak, pelbagai bentuk ü pegmen bertaburan (perang) |
| Skizon matang (penghasilan merozoit) | ü jarang terdapat dalam darah periferi ü saiz hampir memenuhi RBC ü bentuk bersegmen ü merozoit : 8-30 (min 24) ü berpigmen di tengah-tengah (hitam) ü merozoit bentuk bujur dan bulat |
| Peringkat | Huraian |
| Mikrogametosit | ü masa muncul 7-12 hari ü saiz lebih besr dari RBC ü bentuk ginjal / pisang ü kromatin bertaburan (padat di tengah) ü pigmen bewarna coklat hitam (bertaburan) |
| Makrogametosit | ü masa muncul 7-12 hari ü saiz lebih besar daripada RBC ü bentuk bulan sabit ü sitoplasma biru gelap ü kromatin padat di tengah ü berpigmen |
Makrogametosit
Plasmodium vivax
| Peringkat | Huraian |
| Trofozoit awal | ü bentuk cincin ü saiz : 1/3 daripada RBC ü RBC tak membesar ü Kromatin halus ü Tiada pigmen |
| Trofozoit matang | ü Sel darah merah (RBC) membesar ü Vakuol jelas ü Saiz besar ü Sitoplasma bentuk ‘ameboid’ ü Pigmen halus, warna coklat kekuningan terdapat bintik-bintik (byk schuffner’s) |
| Skizon awal | ü Hampir memenuhi RBC ü Bentuk ameboid ü Kromatin – kromatin tak tetap ü Pigmen bertaburan ü RBC membesar/membengkak |
| Skizon matang | ü Saiz hampir memenuhi RBC ü Bentuk bersegmen ü RBC lebih membesar ü Ada 14-24 merozoit (min16) ü Pigmen di tengah-tengah |
| Mikrogametosit | ü Masa muncul 3-5 hari ü Memenuhi RBC yang membesar ü Bentuk : bulat padat ü Sitoplasma : biru pucat / merah muda ü Kromatin : bentuk fibril ü Pigmen : bertaburan, warna coklat |
| Makrogametosit | ü Muncul 3-5 hari ü Memenuhi RBC yang membesar ü Bentuk: bulat padat ü Sitoplasma: biru gelap ü Kromatin padat (periferi) |
Plasmodium malariae
| Peringkat | Huraian |
| Trofozoit awal | ü Bentuk cincin ü RBC tidak membesar ü Saiz 1/3 daripada RBC ü Kromatin seperti spesies lain ü Terdapat juga dalam bentuk ‘BIRD EYE’ ü Mungkin ada pigmen |
| Trofozoit matang | ü RBC tidak membesar ü Saiz kecil ü Bentuk padat, berjalur ü Pigmen kasar, coklat tua, bertabur dalam bentuk rod/gumpalan ü Kromatin : berbintik / berfibril |
| Skizon awal | ü RBC tidak membesar ü Saiz : hampir memenuhi RBC ü Bentuk padat ü Pigmen bertaburan ü Kromatin: bentuk tak tetap |
| Skizon matang | ü RBC tidak membesar ü Saiz hampir memenuhi RBC ü Bentuk bersegmen (daisy head) ü Merozoit (6-12) min 8 ü Pigmen bertaburan di tengah-tengah (warna coklat) / perang |
| Mikrogametosit | ü RBC tidak membesar ü Muncul 7-14 hari ü Saiz: lebih kecil dari RBC ü Bentuk bulat dan padat ü Sitoplasma: biru pucat ü Kromatin berfibril ü Pigmen bertaburan |
| Peringkat | Huraian |
| Makrogametosit | ü RBC tidak membesar ü Bentuk bulat dan padat ü Saiz lebih kecil dari RBC ü Sitoplasma:biru tua ü Kromatin padat (periferi) ü Pigmen kecil |
Plasmodium ovale
| Peringkat | Huraian |
| Trofozoit awal | ü Bentuk cincin padat ü Saiz 1/3 daripada RBC ü Tiada pigmen |
| Trofozoit matang | ü Saiz kecil ü Bentuk padat ü Kromatin besar, bentuk tak tetap ü Pigmen kuning kecoklatan, bertabur ü Tersebar |
| Skizon awal | ü Saiz: hampir memenuhi RBC ü Bentuk padat ü Kromatin: bentuk tak tetap ü Pigmen bersepah |
| Skizon matang | ü Saiz: memenuhi ¾ sel darah merah ü Bersegmen ü Merozoit 6-12 (min 8) ü Saiz merozoit besar ü Pigmen kuning berkumpul di tengah |
| Mikrogametosit | ü Saiz: sel RBC, padat, bulat ü Sitoplasma biru ü Pigmen sama dengan P. malariae |
| Makrogametosit | ü Saiz RBC : padat, bulat ü Sitoplasma biru ü Pigmen dan kromatin sama dengan P. malariae |
SUMBER: Pelajar yang mengambil subjek ini.
IMUNOHEMATOLOGI-DARAH
PENGENALAN
DERMA DARAH...sekiranya anda pernah menderma darah walaupun sekali, anda adalah merupakan insan yang istimewa dan sumbangan yang telah diberikan tidak ternilai harganya!! Sepertimana kita sedia maklum, darah merupakan satu komponen penting dalam perawatan kesihatan. Rawatan kes-kes seperti pembedahan jantung, pemindahan organ, rawatan pesakit-pesakit talasemia, haemofilia dan anemia memerlukan pemindahan darah.
DARAH
Darah adalah tisu perantara yang terdapat dalam semua haiwan tinggi yang berfungsi sebagai sistem pengangkutan dalam badan untuk mengangkut gas, nutrien dan hormon. Darah juga terlibat dalam sistem imunisasi menentang penyakit. Terma perubatan berkait dengan darah bermula dengan hemo- atau hemato- dari perkataan bahasa Greek untuk darah.
JENIS-JENIS PENDERMAAN
Pendermaan darah boleh dilakukan melalui dua cara, iaitu pendermaan darah penuh (whole blood donation) dan pendermaan secara aferesis (apheresis donation).
PENGENALAN
Pendermaan darah penuh dan pendermaan secara aferesis merupakan pendermaan darah yang biasa dilakukan. Darah yang didermakan ini akan diproses di makmal kepada beberapa komponen seperti Plasma, Platelet dan Sel Darah Merah (Packed Cell).
PENGHASILAN SDM DAN SDP
KRITERIA MENDERMA DARAH
Isipadu darah yang diambil bergantung kepada berat badan penderma. Jumlah maksima darah yang diambil ialah 450 ml bagi berat badan melebihi 50 kg. Sekiranya badan di antara 45 hingga 50 kg, kuantiti darah yang diambil ialah sebanyak 350 ml. Keseluruhan proses menderma darah mengambil masa lebih kurang 30 minit. Penderma darah penuh ini boleh menderma setiap 3 bulan sekali.
PENDERMAAN AFERESIS
Pendermaan aferesis ialah pendermaan plasma dan platelet, atau kedua-duanya sekali dengan menggunakan mesin aferesis. Masa yang diambil untuk menderma adalah di antara 30 minit hingga 45 minit bagi Plasma dan 45 minit hingga 75 minit untuk menderma Platelet. Oleh kerana melalui pendermaan aferesis sel darah merah penderma tidak diambil, penderma boleh menderma dengan lebih kerap. Tempoh antara pendermaan ialah setiap 2 minggu sekali.
KRITERIA ASAS MENDERMA DARAH
• Berumur di antara 18 hingga 60 tahun (jika berumur 17 tahun, perlu mendapatkan kebenaran bertulis ibubapa/penjaga)
• Berat badan melebihi 45 kg.
• Sihat fizikal dan mental serta tiada masalah kesihatan yang kronik.
• Tidak mengambil sebarang ubat-ubatan dan tidak mengambil minuman beralkohol dalam jangka waktu terdekat sebelum hari pendermaan.
• Tidak berpuasa dan telah mendapat tidur yang cukup (lebih 5 jam) sebelum menderma darah.
• Menetap di Malaysia sekurang-kurangnya selama 1 tahun (bagi bukan warganegara Malaysia) Berumur tidak melebihi 55 tahun
• Berat badan 55 kg dan ke atas.
• Telah menderma darah penuh sekurang-kurang 2 kali dan pendermaan terakhir tidak lebih daripada 6 bulan.
• Mempunyai salur darah yang sesuai ( besar dan jelas)
PROSES MENDERMA DARAH
• Penderma perlu mengisi borang/kad pendaftaran pendermaan darah.
• Menimbang berat badan
• Menjalani ujian darah bagi mengenalpasti kumpulan darah dan kandungan hemoglobin darah.
• Menjalani sessi kaunseling dengan Pegawai Perubatan / Jururawat.
• Pendaftaran dan penderma diberikan buku penderma darah.
• Seterusnya, proses menderma darah yang mengambil masa di antara 7 - 15 minit.
• Selepas selesai pendermaan dan jarum dikeluarkan, penderma perlu berehat sekurang-kurangnya 10 minit sebelum bangun.
• Penderma akan dihidangkan dengan makanan / minuman ringan
NASIHAT KEPADA PENDERMA SELEPAS MENDERMA
• Selepas menderma,penderma dinasihatkan berehat di katil menderma darah selama sekurang-kurangnya 10 minit. Selepas itu, bolehlah bangun daripada katil sekiranya tiada apa-apa masalah seperti loya, pening, kepucatan atau rasa hendak pitam.
• Penderma juga digalakkan mengambil minuman dan makanan yang telah disediakan selepas menderma.
• Dinasihatkan meminum banyak air selepas dalam tempoh 12 jam selepas menderma menderma Ini adalah untuk mengembalikan cecair yang hilang semasa pendermaan darah.
• Jangan mengambil minuman beralkohol untuk beberapa jam selepas menderma.
• Jangan mengambil bahagian di dalam aktiviti-aktiviti berat seperti payung terjun, menyelam, berenang mendaki gunung serta sukan lasak dalam tempoh 24 jam selepas menderma.
SUMBER : Pelajar yang mengambil subjek ini.
IMUNOHEMATOLOGI-KUMPULAN DARAH KELL
KUMPULAN DARAH KELL
Kumpulan darah KELL merupakan kumpulan darah pertama yang ditemui selepas pembangunan ujian antiglobulin.kumpulan darah ini ditemui pada tahun 1946.darah KELLdiberi nama sempena nama Puan Kellehere iaitu seorang pesakit dimana antibodianti-kelltelah menyebabkan penyakit HDN (Hemolytic Disease of the Newborn ).Sebanyak 25 antigen KELL telah ditemui dengan frekuensi dan populasi yang berbeza.Pada tahun 1949,antigen berfrekuensi tinggi telah dilaporkan.
JENIS-JENIS ANTIGEN KELL
Antigen KELL terbahagikepada dua(2)jenis itu antigen berfrekuensi tinggi dan antigen berfrekuensi rendah. Antara antigen berfrekuensi tinggi ialah ( k, Kpᵇ, Jsᵇ, KEL11, Ko ) dan antigen berfrekuensi rendah pula terdiri daripada ( K, Kpᵃ atau Kpᶜ, Jsᵃ, KEL17 ). Antigen K jarang untuk populasi asia.Antigen ini 9% pada orang kulit putih dan 2% pada orang Afrika Amerika.Manakala antigen Jsᵃ pula pada orang Afrika dan Amerika dengan kekerapan 20%. Antigen Ko pula sangat jarang ditemui.
JENIS-JENIS ANTIBODI KELL
Antibodi KELL terbahagi kepada dua(2) iaitu Anti-Ku(Anti-KEL5) dan Anti-K.
KEKERAPAN FENOTIP %
| Fenotip | African Amerika | Whites |
| K+k- | Jarang | 0.2 |
| K+k+ | 2 | 8.8 |
| K-k+ | 98 | 91 |
| Kp(a+b-) | 0 | Jarang |
| Kp(a+b+) | Jarang | 2.3 |
| Kp(a-b+) | 100 | 97.7 |
| Js(a+b-) | 1 | 0 |
| Js(a+b+) | 19 | Jarang |
| Js(a-b+) | 80 | 100 |
| Ko | Jarang ditemui | Jarang ditemui |
RUJUKAN
Immunohematology,second edition,principles and practice, EvaD. Quinley,m/s 142-145.
SUMBER : PELAJAR YANG MENGAMBIL SUBJEK INI.
DIAGNOSTIK HEMATOLOGI-THALASSEMIA
THALASSEMIA
Penyakit yang merendahkan Haemoglobin darah dan menyebabkan kemusnahan serta kurang penghasilan sel darah merah.
PATOFISIOLOGI
Disebabkan oleh kepincangan sintesis rantai globin samada disebabkan mutasi atau ketiadaan gen a atau b.
JENIS THALASSEMIA
PENYEBAB
Anak bagi pasangan yang memiliki Thalasemia Minor ialah 25% Thalasemia Major, 50% Thalassemia Minor dan 25% normal.
UJIAN SARINGAN THALASSEMIA
Individu Thalasssemia Minor dapat mewariskan gen tersebut kepada anak mereka.
Ujian prenatal untuk diagnos Thalassemia Major pada fetus berusia seawal 10-12 minggu .
Oleh itu, pasangan yang berisiko memerlukan ujian saringan ini.
SIMPTOM
Masalah sum-sum tulang (pembesaran abnormal dan rapuh)
rajah 1 tengkorak kepala berduri (hair-on-end skull)
rajah 2 bentuk muka mongoloid
Pembesaran limpa, hati dan jantung
rajah 3 urin keruh
Jaundis (kulit dan sklera mata kekuningan)
Biasanya tiada simptom bagi Thalassemia Minor (pembawa)
DIAGNOSIS
RAWATAN
Tiada rawatan spesifik bagi Thalassemia Minor
· Transfusi darah akut
· Chelation ferum
· Transplan hematopietik allogenik
· Splenektomi
SUMBER : Pelajar yang mengambil subjek ini.
Google Translate
Search
Labels
Popular Posts
Followers
Kunjungan
Traffic Feed
Koleksi
-
▼
2012
(129)
-
▼
May
(48)
- DIAGNOSTIK HEMATOLOGI-KONSEP ASAS LEUKEMIA
- PARASITOLOGI-MORFOLOGI P. falciparum, P. vivax,
- SITOLOGI-DIPLASIA
- IMUNOHEMATOLOGI-DARAH
- IMUNOHEMATOLOGI-KUMPULAN DARAH KELL
- DIAGNOSTIK HEMATOLOGI-THALASSEMIA
- IMUNOHEMATOLOGI-DARAH O BOMBAY
- DIAGNOSTIK HEMATOLOGI-TALASEMIA
- DIAGNOSTIK HEMATOLOGI-SYSTEMIC LUPUS ERYTHROMATOSU...
- DIAGNOSTIK HEMATOLOGI-Penyediaan Hemolysate.
- DIAGNOSTIK HEMATOLOGI-Leukemia
- DIAGNOSTIK HEMATOLOGI : Pembilang Sel Platlet.
- DIAGNOSTIK HEMATOLOGI : Pembilang Sel Darah Putih.
- DIAGNOSTIK HEMATOLOGI : Mengkaji Peralatan Pembila...
- DIAGNOSTIK HEMATOLOGI :Penwarnaan Leishman
- DIAGNOSTIK HEMATOLOGI :Demostrasi cara pengambilan...
- DIAGNOSTIK HEMATOLOGI-Ujian Denaturasi Alkali
- DIAGNOSTIK HEMATOLOGI-Ujian kerapuhan osmosis ( Os...
- IMUNOHEMATOLOGI-Pungutan Dan Pemprosesan Contoh Da...
- IMUNOHEMATOLOGI-Keselamatan Makmal dan Kewaspadaan...
- PARASITOLOGI-TEKNIK PERWARNAAN KEKAL
- PARASITOLOGI-PENGENALAN KEPADA PARASIT MALARIA
- PARASITOLOGI-TEKNIK KEPEKATAN
- PARASITOLOGI-Pemeriksaan Feses
- PARASITOLOGI-KAJIAN LAPANGAN
- PARASITOLOGI-FILARIASIS(PENYAKIT UNTUT)
- BIOKIMIA : SIMBOL-SIMBOL DI DALAM MAKMAL
- BIOKIMIA : Penaksiran Aras Kreatinin Dalam Urin
- BIOKIMIA : Menaksir Aras Glukosa Darah.
- BIOKIMIA : KAEDAH-KAEDAH PENGANALISAAN BIOKIMIA
- BIOKIMIA : Urinalisis
- BIOSTATISTIK : CONTOH BORANG KAJI SELIDIK
- BIOSTATISTIK : PENGANGGARAN SELANG / MIN
- BIOSTATISTIK :PENGUJIAN HIPOTESIS
- BIOSTATISTIK : KHI KUASA DUA ( X2 )
- SITOLOGI- KANSER PANGKAL RAHIM (SERVIK)
- SITOLOGI-CIRI KESELAMATAN MAKMAL
- SOSIOLOGI-TOKOH SOSIOLOGI ( HERBERT SPENCER )
- ENGLISH – JOB INTERVIEW
- ENGLISH – DEBATE
- BIOKIMIA : HIPERGLISEMIA
- BIOKIMIA : DISFUNGSI GINJAL
- BIOKIMIA : Menaksir Kolesterol Bebas dalam Darah.
- BIOKIMIA : Menaksir aras kreatinin dalam serum dan...
- PARASITOLOGI :TEKNIK APUSAN FESES LANGSUNG
- BIOKIMIA : ALAT RADAS DI DALAM MAKMAL BIOKIMIA
- Anatomi : Tekanan Darah
- Anatomi : Morfologi
-
▼
May
(48)
koleksitugasan.blogspot.com

![clip_image004[4] clip_image004[4]](https://blogger.googleusercontent.com/img/b/R29vZ2xl/AVvXsEhaS1Bi-LgRjtYnOiTtt7-WqGjfQwIHu3Vf1SOuYjaqmAif2VwYwh1KNVRihztusxUhZ0ch4O6Zy8ajcIvxR_uCKdvPxhb6LLEWav6VnHwHNfwia-LaT6jTKoLQBfN7Smr9fs9LdMvikDY/?imgmax=800)
![clip_image004[6] clip_image004[6]](https://blogger.googleusercontent.com/img/b/R29vZ2xl/AVvXsEjP024oynpWGlibKy6X7krAWILkda3xXRDi-AJnvFvWIx5To5rhlg5YpjhOpV4USIT-2VA93SJXkKomFRbBCYXN6eflxB_4sx4vE_4OS3eprmrRQAHlZVdq0BUS6RimuXsnur2LgRHedlc/?imgmax=800)
![clip_image006[4] clip_image006[4]](https://blogger.googleusercontent.com/img/b/R29vZ2xl/AVvXsEiD6oDSCWk_nJ6I1QWxHEKmRWb3WdX9sQDCizgF8ivR1H0GYhMSmi5w4aORHLPz_MHQko8S3fc3-w-wVnPlNOnlh5Ehh4sEDJQQrjusOjhhRcOj4VUKC2l9qCdhD2_VGiUyqkH3c36ikko/?imgmax=800)

![clip_image004[8] clip_image004[8]](https://blogger.googleusercontent.com/img/b/R29vZ2xl/AVvXsEiD7Rx_PzCt_ewpOnu5ZYDLZR4L6-7yGMXXzDp89SybfDoTGUnEMUWkpqIaaD9_NkdjxHlqrt_B1LARwQWd0oRgyzz9NpbNZ9Sym1_gF12OE4QBEiTqECXYYOI4EKLvK_056doD3yuUZA4/?imgmax=800)
![clip_image006[6] clip_image006[6]](https://blogger.googleusercontent.com/img/b/R29vZ2xl/AVvXsEgcvunOxAc7g1mAl6uBsiwqul0Gqk3iXRTGNbV633-vLCU83fbWjs9EgRhOM8GSa6h9j5MmI98jN16BpDsahhqbeNgsPXPlBsre0tkBn4QDQrW3X0R_kZfg1ikWbgEK1MAGr_LBlXnjf7E/?imgmax=800)